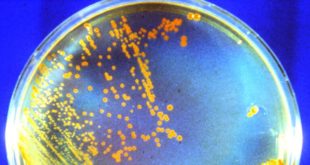

V letokruzích stromů nacházíme proměnlivý podíl izotopu radioaktivního uhlíku C-14. Nejde teď o to, že tento izotop se rozpadá, což je podstatou nejpoužívanější datovací metody v současné archeologii. Z druhé strany uhlík C-14 vzniká při dopadu vysokoenergetického záření do horních vrstev atmosféry. Z letokruhů (dokážeme-li je datovat jinak, tedy přes …
Read More »Pozemská bakterie Conan by mohla pod povrchem Marsu přežít až stamiliony let
Nová studie tvrdí, že už těsně pod povrchem Marsu dokážou i některé pozemské bakterie přežít mnohem déle, než se dosud předpokládalo. Jsou-li chráněny před kosmickým zářením a slunečním větrem, v podobě spor mohou přetrvat až po „geologický čas“. Brian Hoffman a Ajay Sharma z Northwestern University coby spoluautoři nového výzkumu …
Read More »Aktinium-225: nejslibnější zářič alfa pro léčbu nádorů
Ústav jaderné fyziky AV ČR uzavřel dlouhodobou dohodu o spolupráci s německou firmou Eckert & Ziegler AG, která se specializuje na výrobu radionuklidů pro lékařské účely. Německý partner investuje do vybavení a vědeckých experimentů směřujících k výrobě aktinia-225 (225Ac), izotopu, jenž je účinnou složkou léčiv onkologických onemocnění. Firma naopak získá …
Read More »Zdrojem antihmoty mohou být i pulsary
Na Zemi dopadá relativně velké množství pozitronů. Pokud předpokládáme, že ve vesmíru, nebo alespoň v naší části vesmíru, antihmota vzniká pouze radioaktivním rozpadem některých jader a tvorbou párů částice-antičástice z energie, pak je přicházející antihmoty víc, než by mělo. Alespoň tedy podle některých odhadů/modelů. Spektrometr na Mezinárodní kosmické stanici (Alpha …
Read More »Jak testovat radiační odolnost elektroniky v satelitech
CubeSaty jsou schopny létat na oběžné dráze po dlouhou dobu, ale často dochází k přerušení mise kvůli poruchám elektrických systémů, palubních počítačů nebo komunikačních modulů. Illia Zymak z výzkumného centra ELI Beamlines uspěl se svým projektem „Development of a novel electron radiation effects and charging test platform for CubeSat-dimensioned devices …
Read More »Životnost kvantových počítačů omezuje kosmické záření
Praktické využití kvantových počítačů závisí nejen na počtu qubitů, které dokážeme provázat, ale i na tom, jak dlouho dokážeme zapletený stav udržet, než dojde ke kolapsu vlnové funkce (dekoherenci). V současnosti nejstabilnější kvantové počítače (qubity na bázi supravodičů) dokáží výpočty provádět v řádu stovek mikrosekund. Viz také o novém experimentu: …
Read More »Vědci navrhují beta rozpad bez vzniku neutrin
Pokud by mohlo docházet k této reakci, znamenalo by to, že neutrina jsou současně svými vlastními antičásticemi. Vědci z laboratoře Facility for Rare Isotope Beams na Michigan State University ve spolupráci s odborníky z University of North Carolina-Chapel Hill a španělské Universidad Autonoma de Madrid vypracovali teoretický model pro speciální …
Read More »Nemocnice potřebují stále více radiologických fyziků
Počet přístrojů pracujících s ionizujícím zářením, jako jsou různé typy klinických urychlovačů, mamografy či výpočetní tomografy (CT), v českém zdravotnictví významně roste. Za posledních 15 let se počet lineárních urychlovačů i CT téměř ztrojnásobil. Mimo to existují i diagnostická zařízení, především v nukleární medicíně, která detektují ionizující záření, ale sama o sobě …
Read More »Vodík a rentgenové záření
Ionizující záření ve vodě: Kvantový valčík protonu s elektrony Skupina teoretické fotodynamiky na Ústavu fyzikální chemie VŠCHT Praha ve spolupráci s německými a francouzskými kolegy popsala soupeření mezi různými způsoby, kterými se molekuly zbavují energie získané rentgenovým zářením. Práce vyšla v časopise Nature Communications a je pokračováním několikaletého úsilí týmu, díky kterému začínáme rozumět …
Read More »Kosmický had Apep, blízká supernova se zábleskem gama
Co je to Wolf-Rayerova hvězda? Dalekohled ESO/VLT pozoroval spirálovitý útvar vzniklý interakcí hvězdných větrů. Tento působivý záběr nově objevené hmotné trojhvězdy pořídil dalekohled ESO/VLT vybavený přístrojem VISIR. Díky svému vzhledu dostala soustava přezdívku Apep, která odkazuje na staroegyptského boha Apofise majícího podobu obrovského hada. Mohlo by se jednat o první …
Read More » Sciencemag.cz
Sciencemag.cz